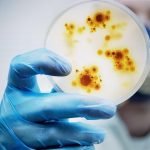

Por Diego Recinos
El domingo por la mañana, un hombre de 91 años de Mjölby, junto a dos mujeres adultas mayores, fueron los primeros suecos en recibir la vacuna de Pfizer y Biontech contra COVID-19.
El domingo comenzó la vacunación en Suecia. Gun-Britt Johnsson, de 91 años, vive en la residencia de ancianos de Boken en Mjölby en Östergötland. A las 8:00 de la mañana, se convirtió en la primera persona en el país en recibir la vacuna de Pfizer y Biontech.
«Fue una sorpresa. Pero es bueno. Entraron en la habitación y me preguntaron si quería. Se siente bien, para que no se enferme», dijo Gun-Britt Johnsson, después de recibir la vacuna en el salón de actos del alojamiento.
El sábado por la mañana fue cuando llegó a Suecia la primera entrega de la vacuna de Pfizer y Biontech. Las 9.750 dosis llegaron en camión desde la fábrica de Bélgica y son suficientes para unas 4.900 personas. Luego, el envío se distribuyó a las 21 regiones del país, varias de las cuales comenzaron a vacunar el domingo.
En Estocolmo, Stig Selin, de 76 años, en el alojamiento especial Attendo Sabbatsbergsbyn fue el primero en ser vacunado en el brazo. «Se siente bien, muy bien. No dolió», comentó Stig Selin.
Selin dijo que nunca dudó en vacunarse y no se preocupa por los efectos secundarios. También insta a quienes no estén seguros a que se vacunen de todos modos. «Ve y vacúnate. No lo dudes», mencionó.
El domingo, unas 400 personas recibieron la primera de dos dosis de la vacuna de Pfizer y Biontech.

En la primera entrega de vacunas, la región de Estocolmo, Västra Götalandsregionen y la Región de Skåne recibieron 425 dosis cada una, mientras que las otras 18 regiones recibieron 200 dosis cada una. A partir de la última semana de diciembre, se espera que se entreguen alrededor de 80.000 dosis cada semana en Suecia. Aún se desconoce exactamente qué día tendrá lugar la próxima entrega.
Los primeros en ser vacunados son los ancianos en viviendas especiales o con atención domiciliaria y el personal que trabaja con estos en el cuidado y la salud. También se da prioridad a los adultos que viven con una persona que recibe atención domiciliaria.
En total, unas 600.000 personas están incluidas en los principales grupos prioritarios, que según el gobierno estarán completamente vacunados en abril. Se espera que toda la población mayor de 18 años, así como las personas más jóvenes en grupos de riesgo hayan recibido la vacuna durante la primera mitad de 2021.